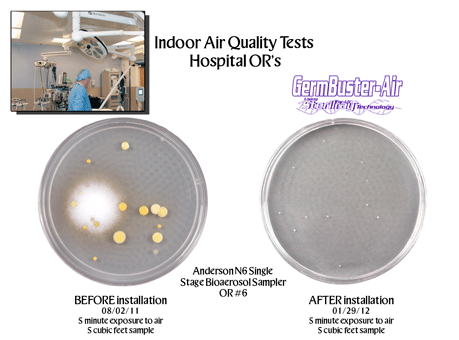
IAQ-OR6-02
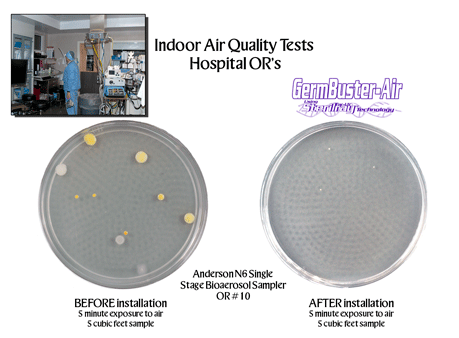
IAQ-OR10-01

|
||||||||
|
|

ONE FIFTH OF A SECOND...
That's all it takes for Far-UV Sterilray to eliminate 99.98% of the world's most harmful bacteria at 500 cfm in an airstream. With unmatched speed, convenience and effectiveness, the GermBuster-Air is changing the world of HVAC air handling installations through its groundbreaking use of Far-UV technology.
MOST UV PRODUCTS DEACTIVATE PATHOGENS...FAR-UV DESTROYS PATHOGENS.
The secret is a patented technology that uses Far-UV, a wavelength high in photon energy that is up to 1,000 times more effective than germicidal UV-C technology. Far-UV Sterilray™ technology destroys rather than alters the DNA of pathogens.
ADVANTAGES:
* One Far-UV lamp replaces up to 20 UV-C bulbs.
* Rugged construction, ready for harsh HVAC environments.
* Not affected by temperature or humidity.
* No electrodes to wear out-Power adjustable.
* Lamp does not contain mercury or other dangerous materials.
* Clears HVAC coils of mold and all other bio-growth.
* Reduces wear and tear, extends the life of HVAC systems.
* Helps minimizes maintenance costs.
* Extends downstream filter life.
THE SAVINGS...
* Clean HVAC coils extend maintenance intervals, and reduce or eliminate
chemical treatments.
* Reduces HVAC cost of ownership.
* Cut HVAC energy costs.
* Cut HVAC maintenance /consumables.
* Increase employee productivity.
* Better IAQ / Reduced health Issues/sick days.
* Lower your building's environmental impact.LOCATIONS & BENEFITS...
Inside Air Ducts
Locate in center of a straight 3 foot section
Kills microbes on the fly in less than 0.2 second exposure
Up to 4 log reduction In a single pass
Disinfects outside make up air immediately – single pass
Kills any bacteria picked up in all air returns
Inside Air Handler Units
Locate between blower intake and evaporator coil grid
Produces same benefits as achieved with air duct installation
Eliminates mold buildup on coils
Keeps all surfaces (including blower) free of bio-material
Operational and maintenance costs savings pay for unit and installation
Downstream of Entrance Fans and Evaporator Coolers
Similar to air duct installation

![]()
Home · About · Technology · Lab Reports · Products · Contact Us
©2017
- Far-UV Sterilray™ All Rights Reserved.